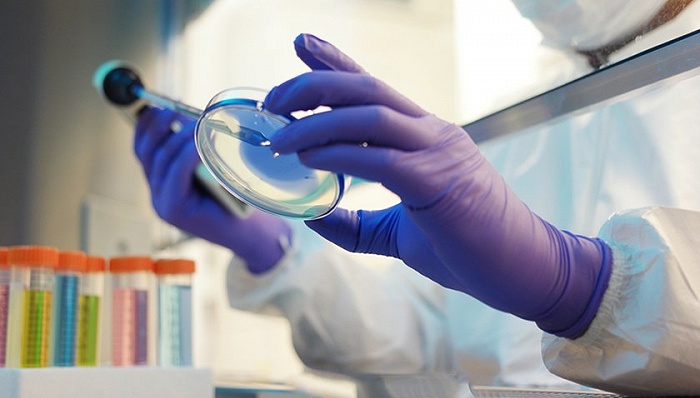

乱占耕地应对指南,最新消息与初学者进阶处理策略
近年来,乱占耕地的现象屡见不鲜,这不仅破坏了土地资源的合理利用,也影响了农业发展和粮食安全,本指南旨在帮助读者了解乱占耕地的最新消息、相关法律法规及应对策略,以便更好地完成相关任务或学习相关技能。了解乱占耕地现象1、...
电视剧隐秘而伟大最新探秘独特小店的小巷故事
随着电视剧《隐秘而伟大》的最新一季火热播出,剧中隐藏的小细节和独特之处引起了广大观众的关注,让我们一同走进剧中隐藏的一条神秘小巷,探寻一家别具一格的特色小店,感受其独特魅力。走进这条小巷,仿佛穿越了时空,回到了旧时的...
最新限塑令实施方案出炉,全面加强塑料管控力度
背景随着人类社会的快速发展,塑料污染问题日益凸显,从塑料袋、塑料瓶到各类塑料包装,塑料制品的广泛使用给环境带来了巨大压力,为了应对这一挑战,全球范围内掀起了一股限塑热潮,经过数年的探索与实践,我国也针对塑料污染问题出...
清华园最新动态,揭秘最新消息🏢🌸
🌼✨ 亲爱的朋友们,你们是否对清华园充满了好奇与期待?就让我带你们一起探索这片充满未来与梦想的学术圣地,分享一些关于清华园的最新消息吧!🏢 学术新动向📚清华园,作为中国顶尖学府,始终站在学术前沿,这里传来了一系列令人...
王者觉悟人机20关最新bug揭秘与探究
王者觉悟人机是王者荣耀游戏中的一项重要挑战模式,旨在通过智能AI对战,提升玩家的游戏技能和策略思维,随着游戏版本的更新迭代,人机挑战的难度也在逐渐提升,王者觉悟人机20关出现了最新的bug,引起了广大玩家的关注和热议...
中美疫情最新动态,自然美景中的探索之旅
随着全球的变化,我们都在关注着每一个重要的消息,尤其是关于疫情的最新动态,让我们暂时放下严肃的话题,聊聊中国疫情与美国最新消息之余,来一场轻松愉快、鼓舞人心的探索自然美景之旅,在这个特殊的时刻,让我们远离尘嚣,寻找内...
四川疫情最新症状揭秘,自然美景之旅成为首选探索之地
疫情阴霾逐渐散去,四川大地迎来新的生机,我们不谈疫情的困扰,来聊聊四川的美景和旅行,让我们一起踏上旅程,探索这片神奇的土地,感受大自然的魅力,远离尘嚣,发现内心的平静。四川,这片美丽的土地,拥有无数令人陶醉的自然风光...
最新要发行的人民币,小巷深处的神秘宝藏揭秘
在繁忙的都市生活中,总有一些安静的小巷,藏匿着许多令人惊喜的秘密,随着全新人民币的即将发行,让我们一同走进一条独特的小巷,探寻一家隐藏在此的特色小店,感受那里的独特魅力。走进这条小巷,仿佛穿越了时空的隧道,远离了都市...
美国最新实时统计数据概览,科技重塑生活的前沿数据魅力
随着科技的飞速发展,美国再次引领全球创新潮流,推出了一系列令人瞩目的高科技产品,我们将聚焦于一款实时统计数据的创新产品,带您领略科技如何改变生活,激发科技爱好者的无限兴趣。前沿设计,尽显科技魅力这款实时统计数据产品采...
关于抗议的最新消息,关于抗议的最新消息深度报道
背景概述随着社会的不断发展,抗议作为民众表达诉求、争取权益的一种方式,屡见不鲜,一场规模空前的抗议活动在全球范围内引发了广泛关注,本报道旨在详细回顾抗议的背景、重要事件、影响及其在特定领域或时代中的地位。抗议起源此次...

京公网安备11000000000001号
京公网安备11000000000001号 京ICP备11000001号
京ICP备11000001号